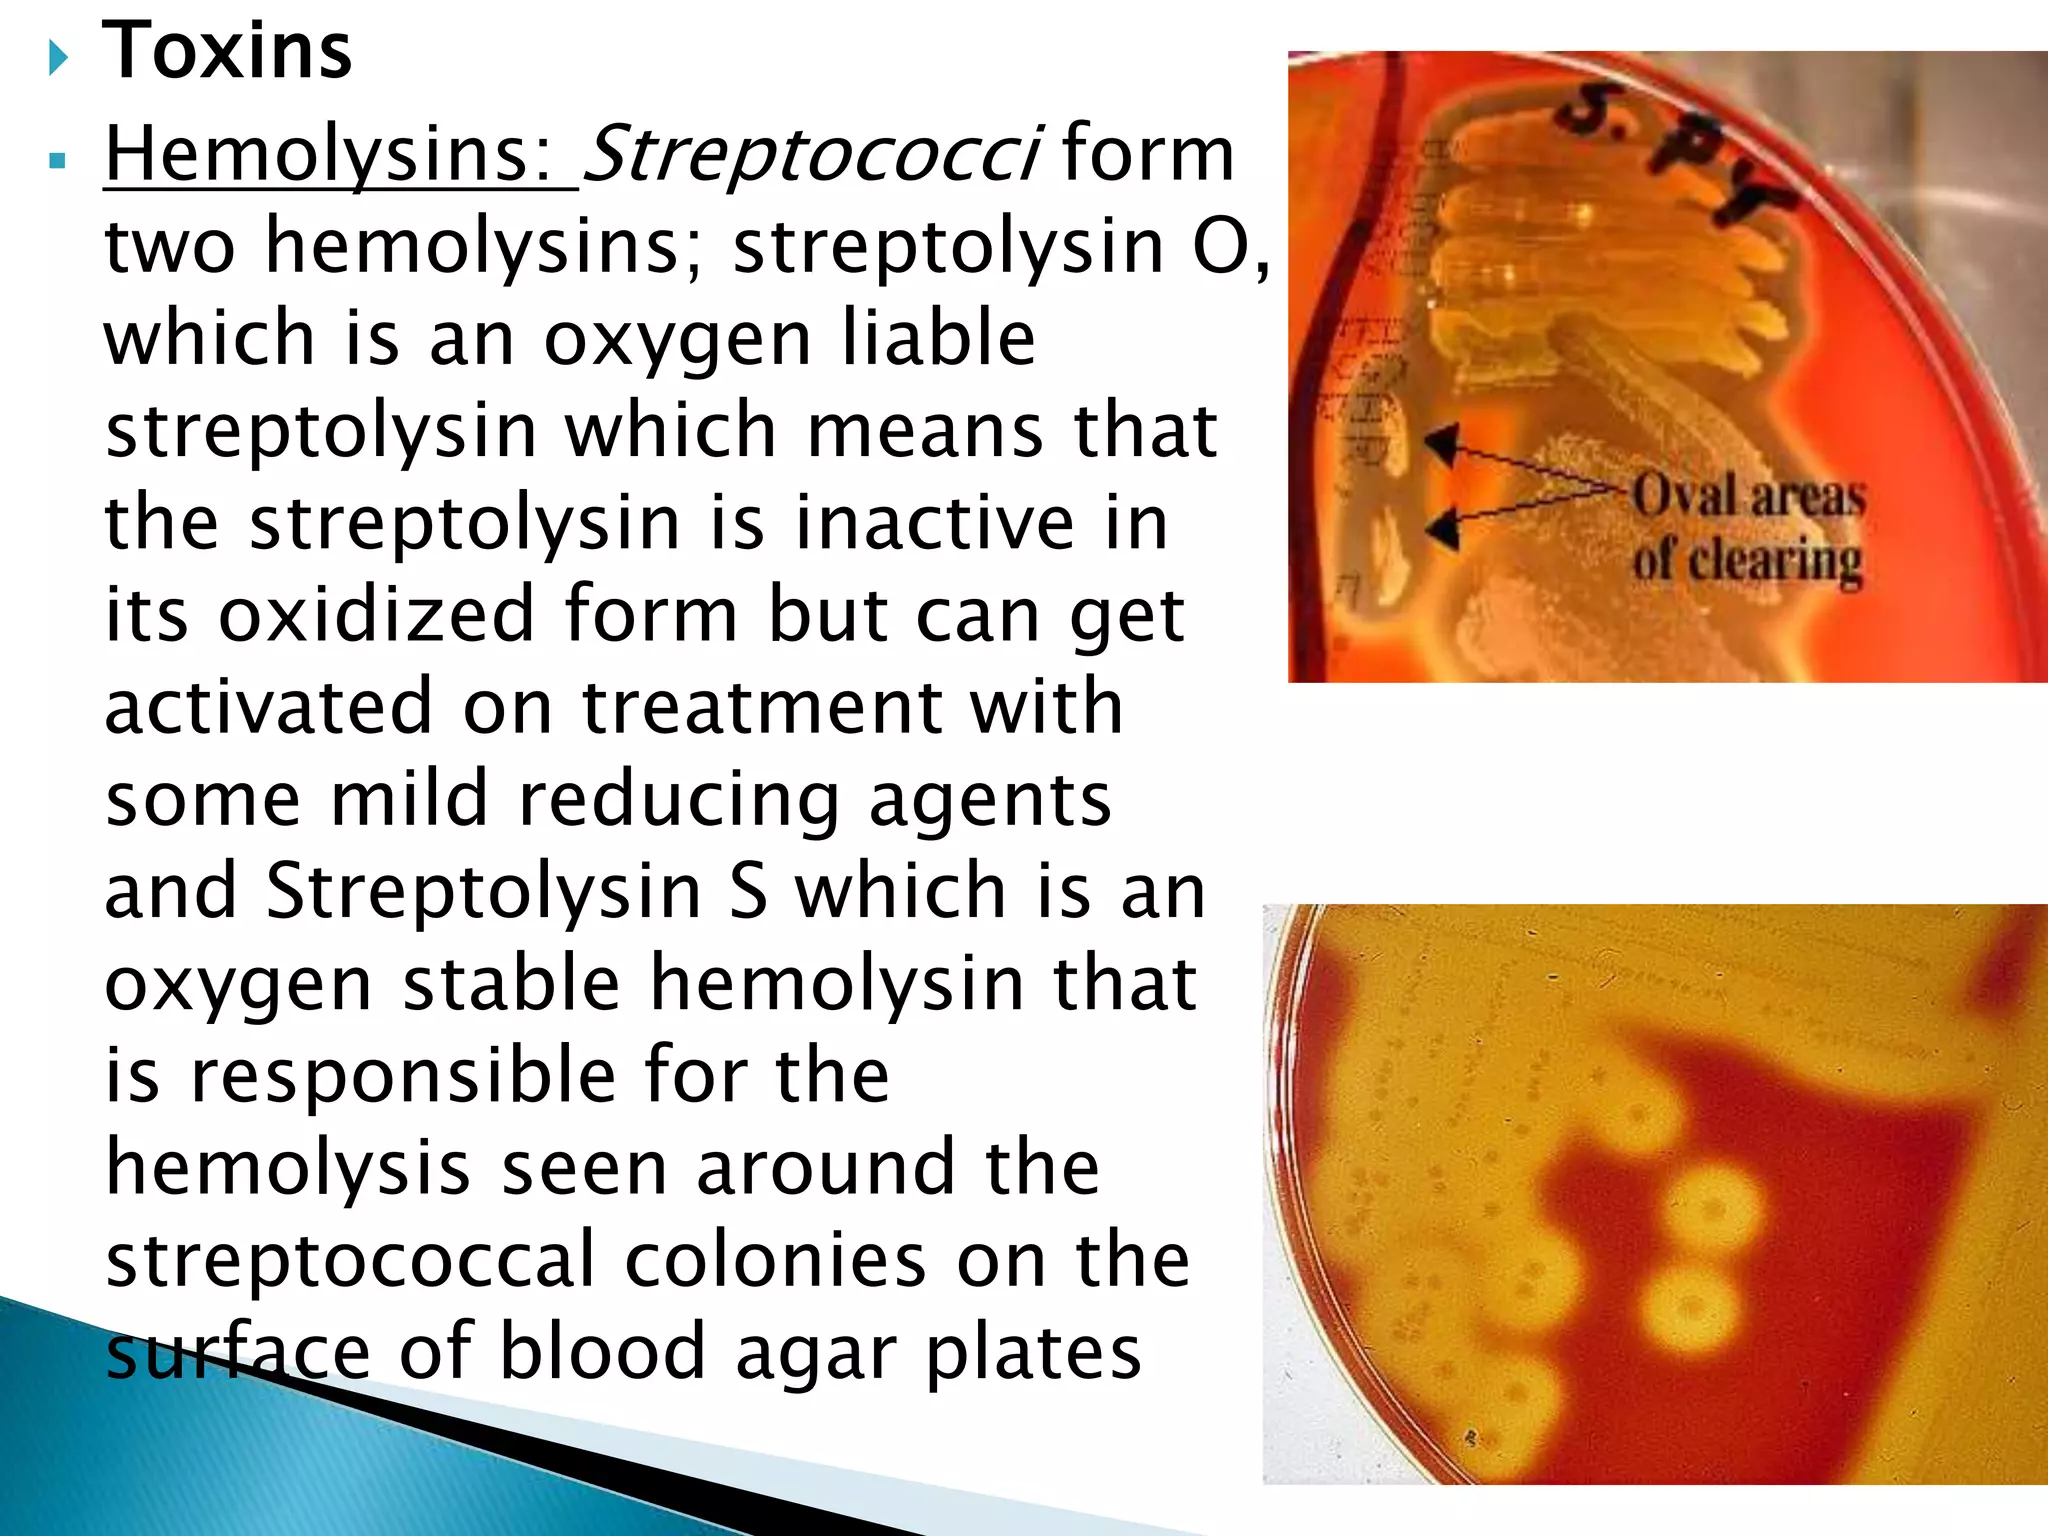
 Toxins
 Hemolysins: Streptococci form
two hemolysins; streptolysin O,
which is an oxygen liable
streptolysin which means that
the streptolysin is inactive in
its oxidized form but can get
activated on treatment with
some mild reducing agents
and Streptolysin S which is an
oxygen stable hemolysin that
is responsible for the
hemolysis seen around the
streptococcal colonies on the
surface of blood agar plates

The document provides a detailed overview of Streptococcus pyogenes, the bacterium responsible for diseases such as pharyngitis and scarlet fever. It covers its historical discovery, virulence factors, pathogenic characteristics, specimen collection methods, diagnostic tests, and antibiotic sensitivities. The diseases primarily affect children and are transmitted through respiratory droplets, with distinctive symptoms like skin rashes and streptococcal toxins involved in their pathogenesis.